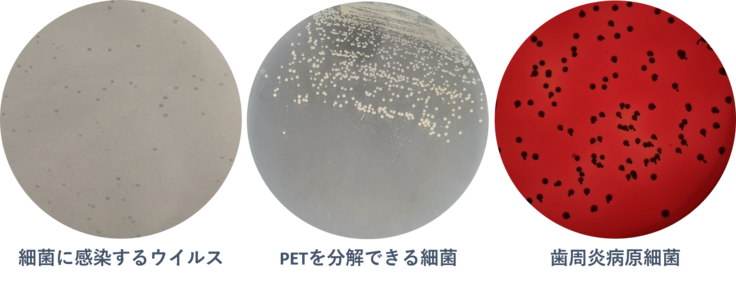

寄付総額
目標金額 600,000円
- 寄付者
- 47人
- 募集終了日
- 2024年7月31日

地域医療を守るため、ともに走ろう|ドクターカー更新プロジェクト
#医療・福祉
- 現在
- 7,037,000円
- 寄付者
- 246人
- 残り
- 30日

HBOCで発症する男性のがん「前立腺がん」早期発見を目指す臨床研究
#医療・福祉
- 現在
- 2,925,000円
- 寄付者
- 62人
- 残り
- 29日

生まれつきの心臓の病気「先天性心疾患」 遺伝子解析から未来の医療へ
#医療・福祉
- 現在
- 8,403,000円
- 寄付者
- 242人
- 残り
- 30日

国宝 彦根城、日本の遺産を未来へつなぐ|高橋架け替えで蘇る大名庭園
#地域文化
- 現在
- 7,985,000円
- 寄付者
- 195人
- 残り
- 37日

通常医療が提供困難な状況で、1人でも多くの命を救うプロジェクト
#国際協力
- 総計
- 11人

情景を共感してもらえる冊子作り/写真展を行いたい
#地域文化
- 現在
- 100,000円
- 支援者
- 1人
- 残り
- 79日

「科学の芽」賞と子どもたちの「好き」を一緒に応援しませんか?
#子ども・教育
- 現在
- 1,900,000円
- 寄付者
- 95人
- 残り
- 11日
プロジェクト本文
終了報告を読む
はじめまして、九州工業大学 前田憲成研究室 博士前期課程2年の入口俊介と申します!
本ページをご覧いただきありがとうございます!
私が所属する前田憲成研究室は、16人の日本人学生と2人の留学生で構成される、国際色豊かな研究室です!
微生物の巧みな化学反応を活用したバイオテクノロジー
をコンセプトに、微生物工学に関する研究を行っています!
大学や研究機関では、私たちの暮らしの豊かさだけでなく、社会課題の解決に繋げるため、日々研究活動が行われています。
研究活動において、異なる分野間のコラボレーションが非常に重要です。
ある分野が抱える困りごとを別の分野が解決することで、成功につながった研究例が多く存在します。
例えば、皆さんが今使用しているPCやスマートフォンも、半導体、電気通信分野など多くの分野が融合することによって生み出され、このページを見ることが出来ているように、分野を横断した研究が今日の私たちの暮らしの豊かさに繋がっています。
私が所属する九州工業大学 大学院生命体工学研究科(以下、生命体)には、全国から工学と情報工学を背景知識に持った、多様な学生が集まります。
本学の持つ多様性や多くの研究室が1つのキャンパスに集まるといった利点を活かして、研究室の壁を越えたコラボレーション研究が行われることで、社会課題の解決に繋がる研究成果の創出が期待できます。
そこで、「私も研究室の壁を越えたコラボ研究を行って、社会課題の解決に繋がる成果を挙げたい!!」と思い、実際に行動に移しました。
しかし!!私は、多くの壁にぶつかることになります…。
壁1:仲間がいない。
前田研究室が位置する4階の研究室は、循環可能化学コース によって、研究室間の連携が進んでいます。
しかし、違う階の学生とは授業が被らず、交流を深めることができておらず、研究内容を知る機会も少なかったです。
そこで、分野を跨いだ成果を創出するために、4階以外の研究室とのコラボ研究を目指しました。
まずは「私が持つ微生物学の知識を活かしてお手伝いできること」を探しました。先生に相談したり、廊下に掲示されているポスターや各研究室のホームページで情報収集を行い、2階の研究室で行われていた抗菌力をもつ材料合成に関する研究に注目しました。
抗菌は微生物学と深い関わりがあり、ヘルスケアの視点から社会問題の解決に貢献できるのではないかと思い、訪ねてみました。
すると、「インプラントの材料の抗菌性を微生物の専門家に診てもらえるのはありがたい。」と喜んで頂き、コラボ研究が開始しました。
コラボ研究の立ち上げまでは辿り着くことは出来ましたが、もっと他の階の研究室を知る機会が欲しかったな...と思いました。
壁2:研究費獲得のハードルが高い。
思いついたアイデアを実現させるには、自ら研究費を獲得する必要があります。
コラボ研究の内容も固まり、準備実験を進めていく中、最初に学内の助成金を調べました。
しかし、研究を目的として申請できるものが少なく、学内からの支援は断念しました。
次に、外部の研究助成金に申請しようとしましたが、
① 実施したい分野の募集がなかった。
② 応募時期が限られていた。(在学期間に受け取ることができない)
など、そもそも申請することができませんでした。
コラボ研究の実現を目指すことで始めて、学生による資金の調達が困難であることを実感しました。
そこで、クラウドファンディングを活用すれば、
①学生が挑戦する姿を発信し、将来に繋げる事ができる。
②クラウドファンディングを活用してコラボ研究を実現した、前例ができる。
と思い、挑戦に至りました。
本プロジェクトは、時期や分野が比較的自由なクラウドファンディングで研究費を獲得し、研究室間のコラボ研究を実行します。これにより、学生の主体的な研究を立ち上げ、成果創出に意欲的な学生に向けて、アイデアを実現するための道筋を示すことを目的とします。
|実施内容
皆様からのご寄付で、研究交流会の開催と3研究室間のコラボ研究を実施します。
・研究交流会の開催
主体的に研究を行う生命体の学生を対象とした研究交流会を実施します。
研究室間の繋がりの強化やアイデアの発見を目的とします。
※プロジェクト成立後、天災等やむを得ない事情によりイベントが開催できなかった場合、延期またはオンラインでの開催を予定しています。
・3研究室間のコラボ研究
テーマ: 口腔内細菌を用いた歯科インプラントの抗菌性試験
超高齢社会である日本の医療現場では、疾病や事故で失った歯の代替となる歯科用インプラントが利用されています。健常な歯と同様に、インプラントに溜まった歯垢は、歯周病の原因になります。
そこで、九工大・中村研究室では、抗菌性をもつインプラントの開発が行われています。
しかし、口腔内におけるインプラントの抗菌性を評価するには口腔内細菌を培養する環境が必要です。通常、材料合成の研究室はそのような環境を持っておらず、培養が簡易な細菌(大腸菌)を用いて試験を行うことが多いです。
前田研究室では、これまでに様々な微生物の培養を行ってきました。
そこで、前田研究室の培養技術を用いて、中村研究室で合成されたインプラントの抗菌性を評価することが出来ます。
さらに、九工大・生命体OBであり、口腔内細菌のスペシャリストである九州歯科大・山﨑助教が参画することによって、コラボ研究の遂行力が高まります。
九州歯科大・感染分子生物学分野では、口腔内の多種多様な微生物によって引き起こされる口腔内疾患に加え、これらの微生物が全身に及ぼす影響について分子レベルの研究を展開しています。
九州歯科大には、口腔内の歯垢サンプルの採取に協力していただく予定です。
材料合成費、菌株・培地購入費など、実験に必要な資金のご寄付をお願い致します。
↓研究内容をもっと詳しく知りたい方
https://www.docswell.com/s/iri_medlab/ZGXRL9-medlab_1#p1
|資金使途
●研究費
<内訳>
材料合成費、菌株購入費、細菌群集構造解析費、実験資材(培地、試薬など)
●研究交流会
<内訳>
会場費、諸経費
|スケジュール
|イベントの継続
学内に学生主体の研究ブームが巻き起こるには、研究交流会を継続して開催する必要があります。研究交流会の他にもOBOGの方々をお招きした交流会も今後開催予定です。
私たちと九工大の研究を盛り上げましょう!
皆様のあたたかいご支援をどうかよろしくお願いいたします...!
プロジェクト代表 入口俊介
【プロフィール】
2019年 福岡県立福岡高校 卒業
2023年 九州工業大学情報工学部生命化学情報工学科 卒業
現在 九州工業大学大学院生命体工学研究科 生体機能応用工学専攻 在籍
【皆様へのメッセージ】
私が九工大 若松キャンパスに通い始めて早くも3年が過ぎようとしています。
M2になった今、私に出来ることは先輩方から受けた刺激を後代に伝えていくことだと考え、プロジェクトの立ち上げに至りました。
日頃から考えていた研究室間の連携をプロジェクトとして形にできたことを大変嬉しく思います。
本プロジェクトは必ず、研究科に活気をもたらすきっかけになります。
九工大には今後も刺激を与えていきます。ご支援のほど、よろしくお願いいたします。
広報担当 仮屋研汰
【プロフィール】
2024年 独立行政法人北九州工業高等専門学校 生産デザイン工学科専攻 卒業
現在 九州工業大学大学院生命体工学研究科 生体機能応用工学専攻 在籍
【皆様へのメッセージ】
高専時代に得た知識や経験を活かし、日々研究に励んでいます。先輩方が過去に築いてくださった研究室間の交流のおかげで、私は不自由なく自分の興味のある研究を行うことができています。そのため、研究者にとって素晴らしいこの環境を絶やすことなく、さらに発展させていきたいと考えています。今後入学するであろう後輩たちの為にも、大学院での研究をより素晴らしいものにするために、皆様のご寄付を心からお待ちしております。
材料合成担当 友原太郎
【プロフィール】
2020年 福岡県立北筑高等学校 卒業
2024年 九州工業大学工学部マテリアル工学科 卒業
現在 九州工業大学大学院生命体工学研究科 生体機能応用工学専攻 在籍
【皆様へのメッセージ】
学部で研究してきた経験を活かして、本プロジェクトをお手伝いできることを嬉しく思っております。
私自身の研究と本プロジェクトの両立を実現し、挑戦する姿を後輩たちに見せていきたいと考えています。
ご支援よろしくお願いします。
材料合成担当 靏本壮也
【プロフィール】
2020年 福岡県立小倉高等学校 卒業
2024年 九州工業大学工学部マテリアル工学科 卒業
現在 九州工業大学大学院生命体工学研究科 生体機能応用工学専攻 在籍
【皆様へのメッセージ】
本研究科内の他の研究室とのコラボ研究の機会を活かして、自分の研究のモチベーションに繋げたいと思っています。
また、前田研と中村研で一丸となり、このプロジェクトが今後の生命体を盛り上げるきっかけとなれるよう頑張りたいと思います。
あたたかいご支援のほど、よろしくお願いします。
顧問 前田憲成教授
【プロフィール】
2006年 九州工業大学大学院生命体工学研究科生体機能専攻博士後期課程 修了
現在 九州工業大学大学院生命体工学研究科 生体機能応用工学専攻 教授
【皆様へのメッセージ】
大学院生が主体的に立ち上げ、提案した本事業へのご支援をよろしくお願いいたします。
生命体工学研究科の魅力の一つは、多くの分野の教員が集まっている組織ではあるものの、学術分野においては中々対等な共同研究は実現していないのが現状です。今回、様々な共同研究テーマを模索し、企画していく中で、前田研究室、中村研究室、九州歯科大学健康増進学講座感染分子生物学分野(有吉教授と山﨑助教)との連携体制による本事業の立案に至りました。是非、分野横断型の研究を進める本事業を成功に導き、次代の生命体工学研究科の土台を作りたいと考えます。
顧問 中村仁准教授
【プロフィール】
2014年 名古屋工業大学大学院工学研究科博士後期課程 修了
現在 九州工業大学大学院生命体工学研究科 生体機能応用工学専攻 准教授
【皆様へのメッセージ】
本事業の立ち上げに際して、入口君から直々に相談があり、彼自身の得意とする微生物に関連した研究分野を主軸に、新たな研究へと拡げたいとの強い意思を打たれて一緒に取り組み始めました。このクラウドファンディングについても、すでに支援金を獲得し先駆的に活動する学生らに入口君自らコンタクトを取りながら、可能な範囲でのプレ実験をしながら、研究の実現性についても吟味し、率先して準備を進めてきたものになります。学生自らの手で研究を推し進める流れが生まれることで、将来的な学内での研究活性化にもつながるものと期待しています。本事業へのお力添えのほど、宜しくお願い申し上げます。
顧問 山﨑亮太助教
【プロフィール】
2016年 九州工業大学大学院生命体工学研究科生体機能専攻博士後期課程修了
現在 九州歯科大学 感染分子生物学分野 助教
【皆様へのメッセージ】
九工大OBとして、プロジェクトを通して貢献できることを嬉しく思います。
次世代の活力ある学生の挑戦を心から応援しています。
大学院での生活を更に実りのあるものに出来るよう、皆様のご支援をよろしくお願いいたします。
髙辻義行准教授
【応援メッセージ】
学生が自分たちの力で研究を進めようとする、その熱意と挑戦する姿勢に感銘を受けています。自分が勉強・研究している分野だけに留まらず、他分野の研究室に声をかけ、研究を展開していく姿は素晴らしいです。新しい発見や成果が生まれ、イノベーションを起こすことを期待し、心から応援しています。困難な道のりかもしれませんが、学生さんたちの努力と情熱が身を結ぶと信じ、貴重な経験をして、成長していく姿を見ることが楽しみです。頑張ってください!
生体機能応用工学専攻事務室 廣渡香代
【応援メッセージ】
この提案を聞いた時の第一声は、「やっと来たー!待ってたよぉ!」です。プロジェクトのメインであるコラボレーション研究からも社会課題を解決したいという想いが溢れています。この取り組みには、きっと、多くの困難が待ち受けていることでしょう。一般的に「成功」の反対は「失敗」と言われますが、それはトラップです。真の反対は、「何もしないこと」です。決断ができないと、何も行動を起こせないということ。小さなことかもしれないが、この決断を下し、行動を起こしたことに、応援する以外には感情が動きませんでした。ぜひ、この決断を応援いただけましたら幸いです。感情を動かされた方、熱い応援をよろしくお願いいたします。
本プロジェクトへのご寄附については九州工業大学(以下「本学」という)へのご寄附となりますので、確定申告を行うことにより、税制上の優遇措置が受けられます。なお、寄附金領収書はREADYFOR株式会社を通じて寄附金が本学に入金された日付で発行いたします。
本学への入金は募集終了の翌々月になりますので、税制上の優遇措置をお考えの方は対象となる年にご注意ください。
≪個人様のご寄附≫
○所得税の控除個人が行った寄附金については、一定額を所得税の課税所得から控除することができる「寄附金控除」の制度が設けられています。寄附金額(当該年分の総所得金額等の40%を上限とする。)から2,000円を除いた額を所得から控除することができます。
寄附者の所得に応じた税率を寄附金額に乗じて、控除額が決定されます。
(寄附金額-2,000円)×(所得に応じた)税率→所得税額から控除
※詳しくは、文部科学省のホームページをご覧ください。
ホームページURL:https://www.mext.go.jp/a_menu/kaikei/zeisei/06051001.htm
○個人住民税の控除本学を「寄附金税額控除対象法人等」として指定している都道府県・市区町村にお住まいの方は、所得税の控除に加えて、翌年の個人住民税の控除を受けることができます。
【個人住民税控除対象の都道府県・市区町村】
・都道府県:福岡県
・市区町村:北九州市、飯塚市
具体的には、寄附金の額から2,000円を控除した額に、県民税率、市町村民税率を 乗じた額(市区町村で指定されていない場合は県民税率のみの率を乗じた額)が、翌年の個人住民税から控除されます。
・北九州市(寄附金額-2,000円) ×10%(県民税2%+市民税8%)
・飯塚市(寄附金額-2,000円) ×10%(県民税4%+市民税6%)
福岡県の条例により、本学への寄附金については、県民税の税額控除対象となっていますが、市町村民税については、各市区町村の条例により取り扱いが異なっております。
控除を受けるためには、本学が交付した寄附金領収書等を添付して申告を行なう必要がありますので、具体的な手続きについては、市町村民税への適用の有無を含め、お住まいの市区町村税務担当課へお問い合わせください。
≪法人様のご寄附≫
本学への寄附金については、法人税法第37条第3項第2号により、寄附金の全額を損金として算入できます。
※詳しくは、文部科学省のホームページをご覧ください。
ホームページURL:https://www.mext.go.jp/a_menu/kaikei/zeisei/06051001.htm
証明書名義:
READYFORアカウントにご登録の「リターン/ギフトの発送先の氏名」を宛名として作成します。
証明書発送先:
READYFORアカウントにご登録の「リターン/ギフトの発送先ご住所」にお送りします。
寄附の受領日(領収日):
READYFORから実行者に入金された日となります。
領収書の発送日:
2024年10月ごろを予定しています。発行までお時間をいただきますが予めご了承願います。
|お名前掲載について
本プロジェクトのギフトのうち、お名前掲載に関する条件の詳細については、リンク先(https://legal.readyfor.jp/guidelines/terms_of_service_index/terms_of_service/#betten)の
「●命名権、メッセージの掲載その他これに類するリターン」をご確認ください。
- プロジェクト実行責任者:
- 入口俊介(九州工業大学・前田憲成研究室)
- プロジェクト実施完了日:
- 2025年3月31日
プロジェクト概要と集めた資金の使途
九州工業大学大学に所属する学生のコラボ研究実現に向けたプロジェクトです。 支援金は、交流会の費用や材料合成、試薬、菌株など研究費として使用します。
あなたのシェアでプロジェクトをさらに応援しよう!
プロフィール
九州工業大学 大学院生命体工学研究科 前田憲成研究室です! 私たちの研究室では、微生物を用いた環境修復・環境負荷低減技術、エネルギー生産技術、健康QOL支援技術の開発を行っています。 微生物好き集まれ!
あなたのシェアでプロジェクトをさらに応援しよう!
ギフト
10,000円+システム利用料

SNSでお名前紹介
●お礼のメールと寄付金領収書(電子)をお送りいたします。
●前田研究室公式Xにて名前を紹介いたします。
- 申込数
- 17
- 在庫数
- 制限なし
- 発送完了予定月
- 2025年2月
30,000円+システム利用料

ビデオメッセージ
●お礼のメールと寄付金領収書(電子)をお送りいたします。
●前田研究室公式Xにて名前を紹介いたします。
●プロジェクト代表からの感謝のビデオメッセージをお送りいたします。
- 申込数
- 2
- 在庫数
- 制限なし
- 発送完了予定月
- 2025年2月
10,000円+システム利用料

SNSでお名前紹介
●お礼のメールと寄付金領収書(電子)をお送りいたします。
●前田研究室公式Xにて名前を紹介いたします。
- 申込数
- 17
- 在庫数
- 制限なし
- 発送完了予定月
- 2025年2月
30,000円+システム利用料

ビデオメッセージ
●お礼のメールと寄付金領収書(電子)をお送りいたします。
●前田研究室公式Xにて名前を紹介いたします。
●プロジェクト代表からの感謝のビデオメッセージをお送りいたします。
- 申込数
- 2
- 在庫数
- 制限なし
- 発送完了予定月
- 2025年2月
プロフィール
九州工業大学 大学院生命体工学研究科 前田憲成研究室です! 私たちの研究室では、微生物を用いた環境修復・環境負荷低減技術、エネルギー生産技術、健康QOL支援技術の開発を行っています。 微生物好き集まれ!